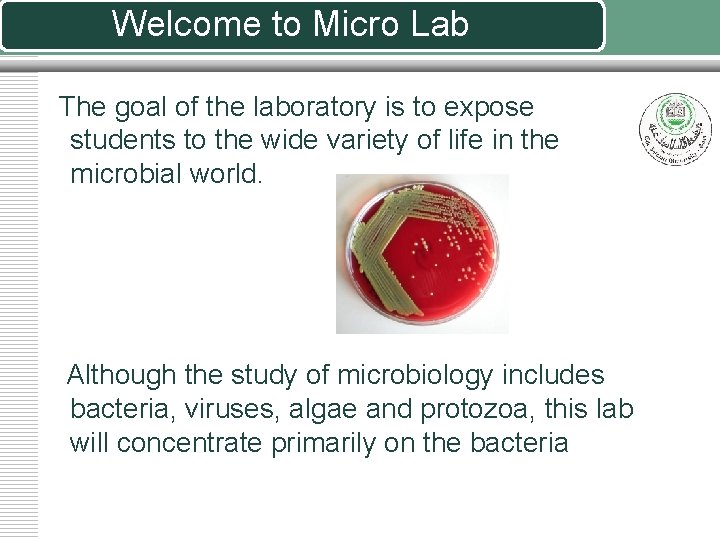
Welcome to Micro Lab The goal of the laboratory is to expose students to

General Microbiology Laboratory Introduction to Micro Lab Welcome

General Microbiology Laboratory Introduction to Micro Lab
Welcome to Micro Lab The goal of the laboratory is to expose students to the wide variety of life in the microbial world. Although the study of microbiology includes bacteria, viruses, algae and protozoa, this lab will concentrate primarily on the bacteria

Microbiological techniques are important in preparing the students for the much harder task of identifying the pathogenic microorganisms in a clinical and environmental specimen. Each experiment with a brief theoretical introduction revealing theoretical basis on which the experiment is based on, so that there will be a strong conjunction between the practical and theoretical sessions. Also included in this manual, the safety precautions that each one in the field of microbiology should know and practice

Bacteria belong to the kingdom Monera. This kingdom contains more biological diversity than all other kingdoms combined. Most people tend to associate bacteria with disease, but less than ten percent of all bacteria cause disease. Many bacteria cannot even live at the temperatures found in and on the human body. In this lab, most of the bacteria with which we will be working are non-pathogenic (do not cause disease). However, some of the bacteria are opportunistic; that is, they can cause disease in an ill or injured person. Therefore, treat all bacteria as if they are pathogenic (cause disease).

Laboratory Safety Rules v 1. Wear a lab coat in lab. We will be working with a variety of materials that can cause permanent stains on some fabrics. Also, a lab coat can help protect from accidental contamination by microorganisms v No eating or drinking during lab. Many pathogens spread by ingested food and drink. In addition, food can carry microorganisms that might contaminate laboratory cultures

Laboratory Safety Rules v Keep long or fluffy hair tied up and out of the way. Hair can contaminate and be contaminated by microbial cultures. v Always wear shoes in lab v Thoroughly wash your hands with soap and water before and after lab. Thorough and frequent hand washing easily and effectively controls the spread of many pathogens.

Laboratory Safety Rules v. Clean the lab bench with disinfectant before and after lab. This helps to prevent contamination of cultures, books, clothing, etc v. Keep the lab bench free of unnecessary materials. Don't use the lab bench as a storage area for coats, books, etc. v. Do not take cultures from the lab area

Laboratory Safety Rules v Dispose all contaminated materials in autoclave bags. When in doubt, ask the instructor. v Immediately report all accidents and spills to the instructor. Cover spills with disinfectant-soaked paper towels for at least 15 minutes before disposing them v Read all assigned materials before the lab session. Experiments will go smoother and have greater chances of success when you know what you will be doing ahead of time

Laboratory Safety Rules v. Treat all microbial cultures as if they are pathogens. Better safe than sorry v. When in doubt, ask the instructor. The only stupid questions are those that are intended as such.

NOTES v 1. Personal belongings are not to be stored in the laboratory. v 2. You will be assigned to a group consisting of four students and you will work together in a semester long project

Lab requirements v. Lab coat v. Matches or lighter v. Soap v. Waterproof permanent marker v. Small or medium size towel v. Sealable plastic bag v. Rubber band v. General Microbiology Manual

Acquaint yourself with microbiology lab Microscope Staining solutions Dettol Microscopic slides Bunsen burner

Acquaint yourself with microbiology lab Forceps Sterile cups Syringes Wooden tongue depressor and swabs Normal saline

Acquaint yourself with microbiology lab Autoclave Incubator

Acquaint yourself with microbiology lab Laminar flow Hood

Acquaint yourself with microbiology lab Culture Plates or Petri Dishes Plastic Loops and Needles Flaming Nichrome loop

Acquaint yourself with microbiology lab Anaerobic Jar Candle jar

Acquaint yourself with microbiology lab Anaerobic station

Acquaint yourself with microbiology lab Enterotube API 20 E

Acquaint yourself with microbiology lab Liquid media in tubes Solid media in tubes

Acquaint yourself with microbiology lab Different forms of slants

Acquaint yourself with microbiology lab Blood culture bottles

Acquaint yourself with microbiology lab Antibiotic disks

Now Try to Identify all the tools and Equipment around you

END OF LECTURE
- Slides: 25